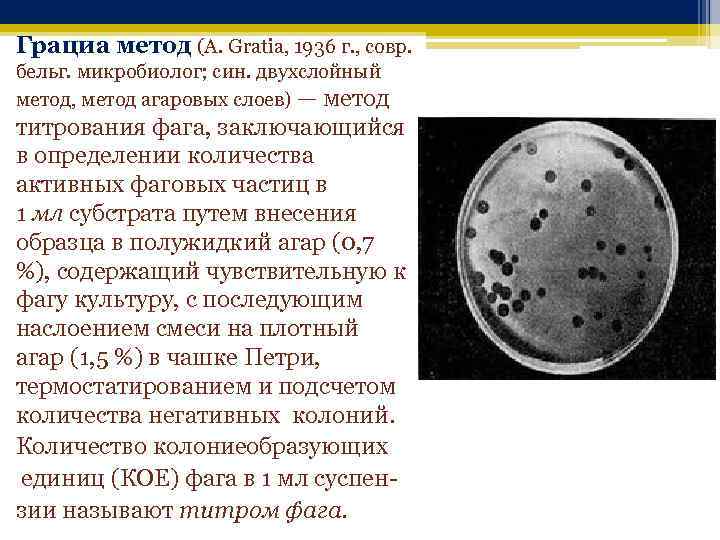

Методы определения бактериофага
Методы определения бактериофага 109 фотографий
Ремонт телевизора на дому хабаровск
Артра таблетки это бад или лекарство
Ходьба в третьем триместре
Музыка к фильму 9 букв
Капилляры тренировка
Где можно сделать зубы рассрочку
Жаль что не родилась мужчиной
Центральная гавань приюта звездных яликов все сундуки
Система тестирования учащихся
Remixicon